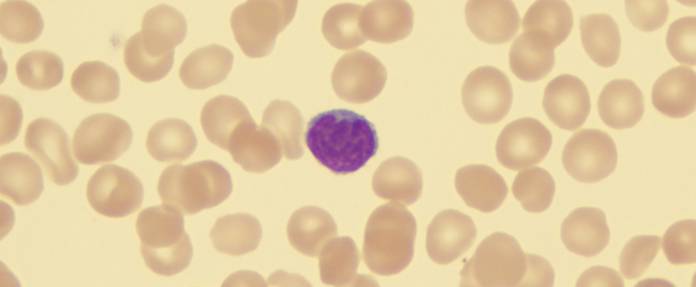

Kugelzellanämie
Eine genetische Abweichung führt zu einer Kugelform roter Blutkörperchen
Die Kugelzellanämie, im Fachkreis als Hereditäre Sphärozytose (HS) bezeichnet, ist eine Gruppe angeborener, verschieden ausgeprägter Defekte der roten Blutkörperchen (Erythrozyten). Auffallend und auch namensgebend ist vor allem deren Kugelform. Normalerweise besitzen Erythrozyten eine scheibenförmige Gestalt. Die Bezeichnung hereditär ergibt sich aus der Vererbbarkeit der Erkrankung. Eine Kugelzellanämie, die unter anderem typische Symptome einer Anämie (Blutarmut) zeigen kann, tritt bereits im Kindesalter mit charakteristischen Merkmalen auf. Die Kugelzellanämie ist häufigster Vertreter der durch Blutkörperchenauflösung (Hämolyse) verursachten erblichen Anämien. Innerhalb Europas findet sich unter 5000 Menschen ein Fall dieser Form der hämolytischen Anämie.
Ursachen
Die Entstehung einer Kugelzellanämie ist genetisch begründet (die Vererbung kann autosomal-dominant oder autosomal-rezessiv erfolgen, sie ist auch durch Neumutation möglich). An der Innenseite der Membran der roten Blutkörperchen kommt es durch genetisch bedingte Defekte zu Funktionsstörungen. Die Membran ist dabei instabiler und Mikrobestandteile gehen verloren. Das Verhältnis von Volumen zu Oberfläche verändert sich auf diese Weise. Hierdurch kommt es wiederum zu Spannungsverlusten und einer Verformung des Blutkörperchens zu einer Kugel. Diese kugeligen Blutkörperchen (Sphärozyten) werden in der Milz zügig abgebaut, wodurch die Entstehung einer Blutarmut (Anämie) begünstigt wird.
Symptome
Eine Reihe medizinisch geläufiger Symptome ermöglicht das Erkennen und die Zuordnung zu dem Krankheitsbild der Kugelzellanämie. Eine Anämie, besser bekannt unter der Bezeichnung Blutarmut, ist ein Mangel an roten Blutkörperchen beziehungsweise an rotem Blutfarbstoff (Hämoglobin). Zumeist ist die Anämie erkennbar durch Blässe und schnelle Ermüdung. Hinzu kommen bei Kindern Störungen der Entwicklung, Unlust zu trinken und Appetitlosigkeit. Schwindel und Kopfschmerzen, auffallend schneller Herzschlag und Atemprobleme bei körperlicher Belastung gehören zu den weiteren Symptomen.
Für die Kugelzellanämie kennzeichnend sind das zusätzliche Auftreten von Fieber und Gelbfärbungen der Haut und Augen (Ikterus, Subikterus) sowie Schmerzen im Oberbauch. Allerdings ist das Erscheinungsbild recht variabel, sodass die aufgeführten Symptome unterschiedlich intensiv ausfallen können. Bei den Patienten liegt eine Vergrößerung der Milz (Splenomegalie) vor, die zu Oberbauchschmerzen auf der linken Seite führen kann. Die Milz lässt sich meist ertasten. Bei einem durch die Hämolyse verursachten Ikterus (Gelbsucht) können zudem größere Mengen an Bilirubin (Abbauprodukt des Hämoglobins) anfallen, was zu einer Gallensteinbildung führen kann (Cholezystolithiasis, Choledocholithiasis). Durch die Gallensteine können sich Störungen des Gallenabflusses ergeben, die ebenfalls eine Gelbsucht auslösen können (posthepatischer Ikterus).
Treten Infektionen auf, kann es zu schwerwiegenden körperlichen Reaktionen wie einer hämolytischen Krise (massiver Abbau von roten Blutkörperchen) und Kreislaufschwäche kommen. Eine lebensbedrohliche Komplikation kann vor allem bei den Ringelröteln, einer Infektion mit dem Parvovirus B19 entstehen, wenn eine zu schlechte Neubildung roter Blutkörperchen (Erythropoese) stattfindet.
Diagnose
Die Diagnose umfasst zunächst die Betrachtung der familiären Auffälligkeiten wie Gallensteine oder erhöhte Bilirubinwerte bei Verwandten. Ein weiterer wichtiger Baustein ergibt sich über Laborwerte, die verschiedene Hinweise geben. Im Blutlabor (kleines Blutbild) fallen niedrige Werte für Hämoglobin (sauerstoffbindendes Protein) auf, wobei das mittlere Volumen der roten Blutkörperchen (MCV) niedrig, der durchschnittliche Hämoglobingehalt (MCH) aber normal sein kann. Die Werte der mittleren Konzentration des Hämoglobins in den Erythrozyten (MCHC) und der Retikulozyten, der noch jungen unreifen roten Blutkörperchen, sind in der Regel erhöht. Bei einer Bewertung der Ergebnisse muss bedacht werden, dass ein stärkerer Abbau der Blutkörperchen nicht immer erkennbar ist, da er durch eine verstärkte Blutneubildung kompensiert werden kann.
Ein weiterer möglicher Test ist die Prüfung der osmotischen Resistenz. Die Widerstandsfähigkeit der Erythrozytenmembran wird dabei gemessen. Die Kugelzellanämie führt zu einer geringeren osmotischen Resistenz.
Der sogenannte EMA-Test richtet sich auf angeborene Membrandefekte der Erythrozyten. Ein Hinweis hierfür ist eine reduzierte Bindung des Farbstoffs EMA (Eosin-5-Maleimid) an die Erythrozytenmembran.
Die Diagnose der Kugelzellanämie beinhaltet weiterhin einen Blutausstrich, mit dessen Hilfe die typische Kugelform der Blutkörperchen, Größenanomalien der Erythrozyten (Anisozytose) und eine unterschiedliche Anfärbbarkeit der Blutzellen (Polychromasie) nachweisbar werden.
Mit Hilfe einer Sonografie (Ultraschall) lassen sich die Milzvergrößerung (Splenomegalie) und etwaige Gallensteine abbilden. Im Rahmen der Diagnose der Kugelzellanämie (Hereditäre Sphärozytose, HS) erfolgt auch eine Einstufung des Schweregrades von 1 bis 4 als
- leichte HS (1)
- mittelschwere HS (2)
- schwere HS (3)
- sehr schwere HS (4)
Differenzialdiagnose
Um eine Kugelzellanämie klar von anderen Erkrankungen abgrenzen zu können, werden mögliche und verbindlich auftretende Symptome abgeglichen. Die drei Bereiche Familienanamnese (Frage nach Erkrankungen bei Verwandten), typische Befunde und hinweisende Laborbefunde bilden hierfür die Basis. So ergeben sich im Labor beispielsweise aufgrund der Membrandefekte Unterschiede bei der Anfärbung der untersuchten Erythrozyten. Differenzialdiagnostisch (bei der Unterscheidung anderer Erkrankungen) müssen bei einem Verdacht auf die genetisch bedingte Kugelzellanämie erworbene Erkrankungen mit einem Abbau von Blutkörperchen (Hämolyse) in Betracht gezogen werden.
Therapie
Die Ursachen einer Kugelzellanämie sind nur bedingt behandelbar, Therapie der Wahl ist die Entfernung der Milz (Splenektomie). Die Entfernung der Milz verhindert, dass die Kugelzellen in der Milz zerstört werden. Die roten Blutkörperchen überleben damit länger und eine Hämolyse wird aufgehalten. Die Milzentfernung sollte allerdings erst nach dem fünften Lebensjahr umgesetzt werden, um den Aufbau des Immunsystems und der Infektabwehr eines Kindes zunächst sicherzustellen. Zudem ist die Entfernung der Milz in leichten Fällen der Kugelzellanämie nicht notwendig. Der Aspekt der Früherkennung und Vermeidung hämolytischer Krisen ist wichtig, um die Notwendigkeit von Transfusionen von Blutzellen möglichst zu vermeiden. Nach dem chirurgischen Eingriff der Milzentfernung sind Impfungen gegen Bakterien (Pneumokokken, Haemophilus influenzae) als Infektionsvorbeugung notwendig.
Prognose
Eine Heilung im eigentlichen Sinne kann nicht erzielt werden. Trotzdem ist eine deutliche Verbesserung des Krankheitsverlaufes durch Vorbeugung und regelmäßige Blutuntersuchungen erreichbar. Schwerpunkte liegen hierbei in der Vermeidung von Komplikationen durch rechtzeitige Infektabwehr und die Verhinderung des übermäßigen Erythrozytenabbaus in Form der Milzentfernung.
Letzte Aktualisierung am 02.09.2021.